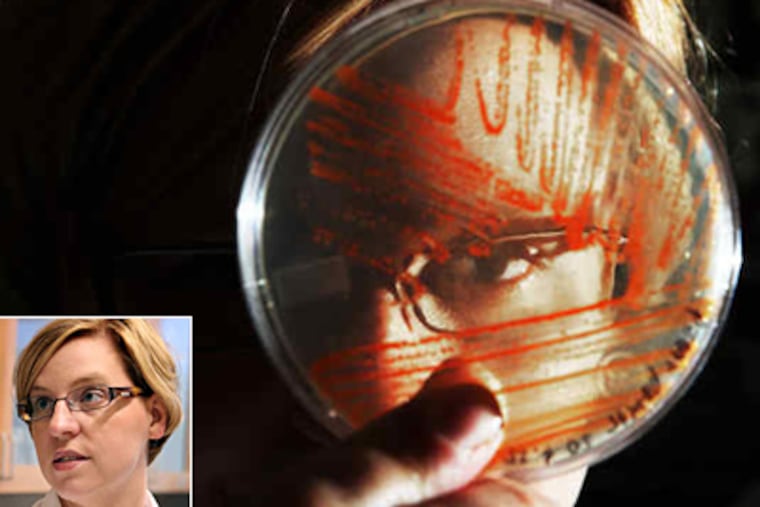
Jennifer Anthony, (also seen in inset), examines a plate of E. coli that is growing a strain of lycopene, the reddish compound in tomatoes. The lycopene resulted after she added four genes to the bacteria.

Finally, something good about E. coli
Scientist makes Vitamin A from it.
Escherichia coli gets a bad rap for making people violently ill, even though most strains are perfectly harmless. You could say it's a bug in need of a good press agent.
Or a biologist such as Jennifer R. Anthony, at the University of the Sciences in Philadelphia.
By inserting a series of carefully selected genes into the microbe, she has turned E. coli into a living factory for making small amounts of Vitamin A.
The goal is to provide a low-cost supply of the vitamin to the developing world, where deficiencies of that nutrient cause widespread blindness and even death.
The early-stage project, in which Anthony's lab has made one strain of the bug with an eye-catching shade of carroty-orange, is part of a fast-growing field called synthetic biology.
Rather than pasting in a single gene here or there, researchers are adding entire genetic pathways to bacteria or yeasts, inducing them to manufacture compounds for uses that range from textiles to automotive fuel. The approach can be a greener alternative to traditional synthetic chemistry.
"We could potentially ask these bacteria to make anything, if we could find the genes for the pathway and put it in," Anthony said.
Before coming to Philadelphia, for example, Anthony was part of a University of California, Berkeley, team that modified E. coli to produce artemisinin, a key drug in the fight against malaria.
Elsewhere, in a joint venture with Tate & Lyle P.L.C., DuPont Co. uses an altered form of the bacteria to produce 1,3 propanediol - a chemical used in the manufacture of both cosmetics and carpets. Other companies are using designer microbes to make diesel fuel.
While there are just a handful of commercialized products made with synthetic biology, more are in the works.
The fast-growing field has spurred some critics to urge caution - warning, for example, that this sort of genetic tinkering could theoretically be used to make chemical weapons.
Such concerns are worthy of discussion, but there is no reason for alarm, said microbiologist Jack Newman, who was at Berkeley with Anthony and is now a senior vice president at Amyris, a California biotech firm that further developed the anti-malaria drug.
"It is rocket science," Newman said. "Not everybody can do this. It's not like a dirty bomb or something."
Anthony, 34, a Wisconsin native who came to the University of the Sciences in 2007, is using the technique to address a serious public-health problem.
Hundreds of thousands of people worldwide do not get enough Vitamin A, leading to widespread blindness and - because the nutrient plays a key role in the immune system - higher rates of death from ailments such as measles and diarrhea.
She decided to start by modifying E. coli because the bacterium naturally makes chemical compounds that belong to the terpenoids, a broad chemical family that includes Vitamin A. Some other members of this family, such as the common solvent turpentine and the cancer drug Taxol, are derived from plants.
But E. coli's natural process for making precursors to terpenoids is tightly controlled. The bacterium makes only enough for its own use, in its cell membrane.
So Anthony's lab inserted a series of eight genes to make the necessary precursors in greater amounts - almost like a second assembly line alongside the first. Six of these genes came from yeast; two were extra copies of genes already present among the 3,200 genes of E. coli.
Then she added an additional four genes, copied from another kind of bacteria, to take those precursors and advance the process further. These genes transform the chemical building blocks first into lycopene - the reddish compound found in tomatoes - and then into beta carotene, the orange compound in carrots.
The lab has made versions of E. coli that produce each of these compounds as a final product, resulting in red and orange bacteria.
But in order to make Vitamin A, she needed to add still another gene - one that could cleave the beta carotene in two. Humans have such a gene; Anthony used a copy of a similar gene from a mouse.
Both animals need such a gene to derive Vitamin A from the beta carotene in vegetables. Contrary to popular belief, carrots do not contain Vitamin A itself.
With the added genes in place, the custom strain of E. coli yielded its first Vitamin A this year. The vitamin is extracted, so there is no bacteria in the final product. (In any event, the lab starts with an even milder strain of the bug than what is typically found in the human gut.)
So far, the amount of vitamin made is quite small, in the range of micrograms per liter of broth. To make the process commercially viable, Anthony needs to increase production by many thousands of times - a feat she expects to achieve in a couple of years.
That will require further tinkering and "optimizing" the strain of bacteria, and determining the best kind of growth medium for it to live. Currently funded by the university, she is applying for federal grants.
Anthony aims to make her process competitive with the current method of making Vitamin A, which uses methanol. That ingredient comes from natural gas or petroleum, and is subject to big price fluctuations.
The exact wholesale price that Anthony's method would be competing against is unclear. UNICEF buys the vitamin to distribute in developing nations for less than two cents a capsule; the bulk of the supply comes from in-kind donations.
The biggest issue in getting Vitamin A to undernourished people is the logistics of distribution, said Alfred Sommer, a leading Vitamin A expert at the Johns Hopkins Bloomberg School of Public Health. Still, he said the work in Philadelphia sounded promising.
"This is the thing that we all sort of dream about - that is, that some commercial venture will take seriously the needs of the developing world," Sommer said. "The fact that they're willing to spend their time and energy and money and creativity on things that by definition need to be sold inexpensively, is terrific."
Consumers in the United States give little thought to Vitamin A. Even if they don't eat enough foods that naturally contain the nutrient, such as eggs, milk and liver, it is routinely added to cereals and bread.
The U.S. Food and Drug Administration recommends a daily intake of 1,500 micrograms, assuming a daily diet of 2,000 calories. A person can easily get the equivalent amount or more from one large carrot.
But in the developing world each day, millions get a small fraction of that amount, Sommer said. So UNICEF distributes large-dose capsules twice a year.
In 2008, the organization gave out more than 540 million capsules, most of them containing 200,000 International Units of the nutrient - equal to 60,000 micrograms. The vitamin is fat-soluble so the body can store the excess in the liver.
For now, it is all made with old-fashioned chemistry. But if Anthony has her way, one day some of the supply could come from a helpful bug.